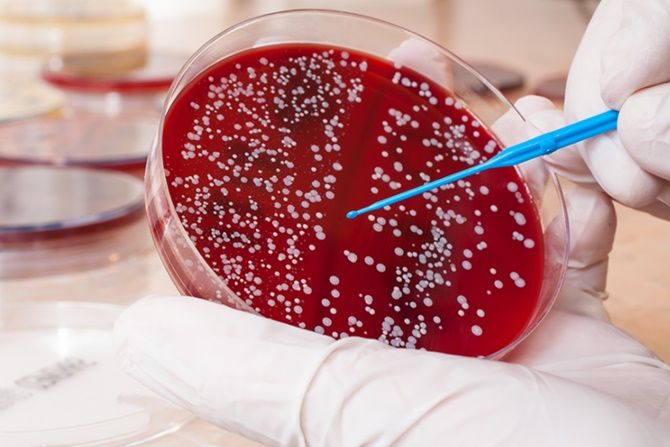
Pasien Thalassemia

Ini Syarat Agar Pasien Thalassemia Tetap Bertahan
THALASSEMIA adalah suatu penyakit kelainan darah. Perjuangan para pasien thalassemia tak mudah. Tetapi mereka tetap masih ada peluang untuk tetap bertahan.
Selain kendala ekonomi dan juga tantangan keluarga dalam menemani pengobatan, mereka juga harus melakukan transfusi darah dan rutin terapi obat. Namanya terapi kelasi besi.
Dalam peringatan Hari Thalassemia Sedunia setiap 8 Mei, PT Kalbe Farma Tbk (Kalbe) mengajak penyandang dan pemerhati Thalassemia dari seluruh Indonesia untuk terus semangat dan disiplin dalam berobat.
Masyarakat diminta untuk bersedia mendonor darah mengingat kebutuhan pasien thalassemia untuk selalu transfusi darah. Dan dukungan keluarga atai caregiver adalah yang utama.
“Bagaimana semua masyarakat ikut mendukung kesehatan masyarakat untuk hidup yang lebih baik, terkhusus pada penyakit yang tergolong langka (rare disease) di mana salah satunya Thalassemia,” ujar Marketing Director Pharma PT Kalbe Farma Tbk. Ridwan Ong dalam webinar baru-bari ini.
Kepatuhan penyandang dalam mengkonsumsi obat sangat berpengaruh terhadap keberhasilan pengobatan kelasi besi. Di samping itu, penyandang juga dianjurkan untuk mengkonsumsi sayuran dan buah-buahan yang banyak mengandung nutrient dan vitamin (asam folat, vitamin E, vitamin C).
Konsultan Hematologi-Onkologi Anak dr. Sri Mulatsih, Sp.A(K), MPH mengatakan, penyakit Thalassemia merupakan penyakit kelainan darah yang diturunkan dari salah satu atau kedua orang tua. Kelainan ini membuat penderitanya mengalami anemia atau kurang darah dan harus diwaspadai karena dapat menyebabkan kompilasi seperti gagal jantung, tumbuh kembang
terhambat, gangguan hati dan ginjal hingga kematian.
“Pengobatan yang diberikan untuk penyintas Thalassemia bisa dilakukan dengan transfusi darah dan pemberian kelasi besi secara rutin untuk meningkatkan harapan dan kualitas hidup lebih baik,” kata dr. Sri Mulatsih.
Terapi kelasi besi adalah terapi yang dilakukan seiring dengan transfusi darah yang dilakukan dengan rutin. Melakukan transfusi darah setiap bulan akan menyebabkan seseorang mengalami penumpukan zat besi dalam darah. Kondisi ini bisa menyebabkan seseorang keracunan, merusak fungsi jantung dan hati. Oleh karena itu, terapi ini dilakukan untuk mencegah terjadinya penumpukan zat besi.
Dalam acara yang sama, Direktur Pencegahan dan Pengendalian Penyakit Tidak Menular Kemenkes dr. Cut Putri Arianie, MH.Kes mengatakan dalam penanggulanan penyakit Thalassemia ini, pemerintah telah menerapkan 3 pilar yaitu promosi kesehatan, deteksi dini, dan penanganan khusus. Untuk promosi kesehatan dilakukan dengan memberikan informasi kepada masyarakat tentang penyakit Thalassemia bagaimana mencegah dan mengobati.
Untuk deteksi dini dilakukan khususnya pada orang terdekat penyandang Thalassemia. Dan terakhir untuk penanganan khusus biasanya dilakukan di rumah sakit.
Ia juga menambahkan penyakit Thalassemia ini merupakan masalah yang perlu perhatian khusus karena menurut data dari Yayasan Thalassemia Indonesia sudah hampir 11 ribu penyandang Thalassemia. Dengan pembawa sifat sendiri sekiar 6-10 persen jumlah penduduk Indonesia.
Selain itu, bagi keluarga yang memilik anak penyandang Thalassemia juga perlu diperhatikan, dikarenakan akan menimbulkan dampak psikologi dan ekonomi yang cukup berat. Sebab harus melihat anaknya melakukan transfusi darah seumur hidup dengan kebutuhan biaya yang cukup besar. Terlebih, sayangnya belum semua fasilitas kesehatan mendukung dalam melakukan transfusi darah. Dan juga jarak fasilitas kesehatan dengan rumah penyandang Thalassemia yang kadang membutuhkan perjalanan yang cukup jauh.
“Untuk itu dibutuhkan kolaborasi antara pemerintah, pihak swasta, media, akademisi, komunitas dan masyarakat agar pencegahan penyakit Thalassemia bisa dilakukan sejak dini,” kata Cut Putri.(tur)



